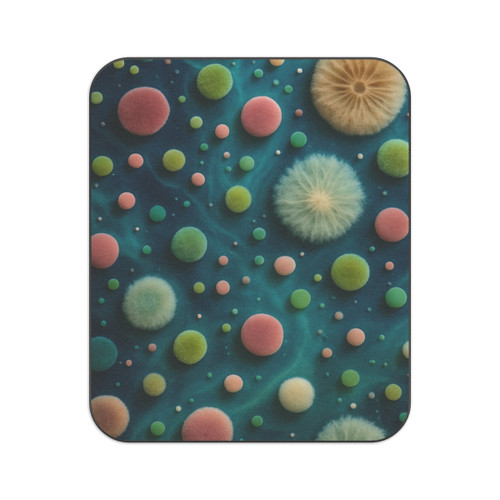
Microbial Galaxy - Picnic Blanket

Product Overview
Wrap your little explorer in the wonders of the universe with the Microbial Galaxy Toddler Blanket. Crafted from ultra-soft, breathable material, this enchanting blanket features vibrant cosmic designs that not only keep your toddler cozy but also inspire their imagination. The playful colors and whimsical patterns create a magical atmosphere in any room, turning nap time into an adventure among the stars. Designed for easy care and durability, it’s perfect for everyday use-making it an essential addition to your child’s bedroom or play area. Let your child's dreams take flight with the Microbial Galaxy blanket!
Product features
- 100% Polyester for exceptional durability
- Soft fleece material for a gentle touch
- Double-needle topstitch for long-lasting quality
- Vibrant colors from advanced printing techniques
- Medium-heavy fabric (8.5 oz /yd²) for warmth
Care instructions
- Machine wash: cold (max 30C or 90F)
- Non-chlorine: bleach as needed
- Tumble dry: low heat
- Do not iron
| 30" × 40" | |
|---|---|
| Width, in | 30.00 |
| Height, in | 40.00 |